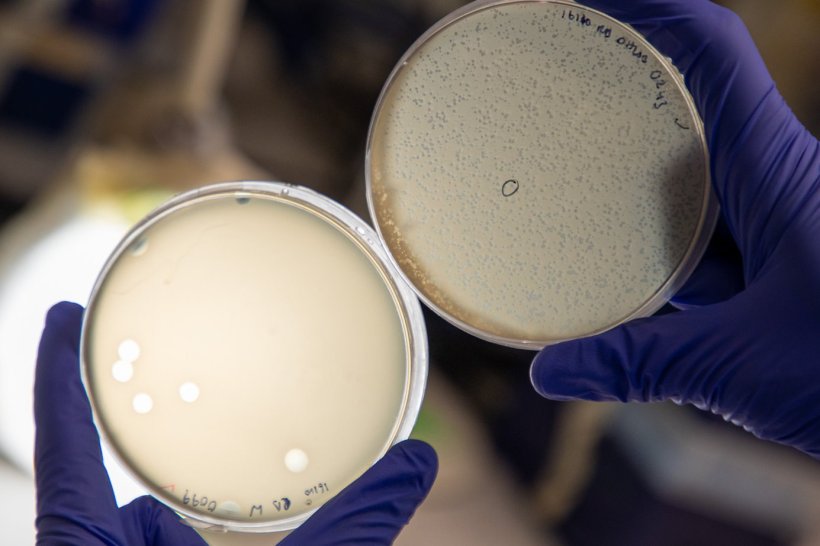
Two petri dishes containing bacteria cultures held up by two hands in blue...

Image source: University of Southampton
News • Bacteria-eating viruses
New phages spark hope against hospital superbug
Potential treatments for Klebsiella pneumoniae, one of the world’s most dangerous hospital pathogens
An international team of researchers led by the University of Southampton and funded by Bowel Research UK have comprehensively catalogued a new collection of bacteria-eating viruses called phages sourced, in part, from hospital wastewater. The phages in the collection have been shown to be effective against different strains of Klebsiella pneumoniae - a type of bacteria that has become a serious threat in hospitals because of its growing resistance to multiple antibiotics.
While phages that target Klebsiella are increasingly being documented in research, their clinical use has been slowed by fragmented access to data on phages and which bacteria they target. To speed up research and treatment development, the researchers have made the new collection open source and publicly available at www.klebphacol.org. It’s been detailed in a paper published in Nucleic Acids Research.

Image source: University of Southampton
Dr Franklin Nobrega, Associate Professor in Microbiology at the University of Southampton and project lead, whose work is supported by Bowel Research UK, said: “Making the Klebsiella Phage Collection open access is crucial. It means scientists everywhere can both use and build on it. Researchers can request samples of phages and bacterial strains for their own studies, compare results across labs, and even contribute new phages and strains to the collection. “By sharing these resources openly, we’re breaking down barriers that have slowed progress and creating a truly collaborative global effort to tackle antibiotic resistance.”
Klebsiella can cause serious infections such as pneumonia, bloodstream infections, and urinary tract infections—particularly in hospital patients or people with weakened immune systems. Health officials are particularly concerned as some strains are developing resistance to multiple antibiotics, including those used as a last resort when others have failed.

Image source: University of Southampton
Different phages work a bit like different keys - each one can only “unlock” (infect) certain strains of the bacteria. The Klebsiella Phage Collection fully characterises 52 different phages, alongside 74 strains of Klebsiella. These phages come from five viral families, including a newly discovered group linked to the human gut. Previous studies have suggested that some strains of Klebsiella are associated with inflammation in the gut, potentially worsening inflammatory bowel disease (IBD).
Dr Nobrega commented: “Some of these newly identified phages can be found in people’s guts across the world, in everyone from pre-term babies to older adults. They were found in healthy guts, so we know they are important for good gut health. The presence or absence of certain phages can predict how severe diseases like bowel cancer and IBD are going to be, so our discovery, along with our new library of phages, paves the way for more research to understanding more about these diseases and ultimately improve treatments.”
Kathryn Pretzel-Shiels, CEO of Bowel Research UK, said: “Research like this is crucial in understanding the best way to harness the power of the microbiome to prevent and treat bowel conditions. We're enabling more research to help scientists fully understand the role our gut microbiome plays in maintaining a healthy gut and protecting us from bowel disease.”
The hope is that this phage library will not only support new treatments but also improve understanding of how phages and bacteria interact - knowledge that could prove vital in the fight against antibiotic resistance.
Recommended article

Article • Bacterial defense mechanism
Antibiotic resistance: a global threat to healthcare
Antimicrobial resistance (AMR) is becoming more prevalent around the world, constituting a serious threat to public health. When bacteria acquire resistance against antibiotics, common medical procedures – for example, in surgery – become impossible due to the high infection risk. Keep reading to find out about AMR research, development of new antibiotics and antibiotic alternatives.
Source: University of Southampton
25.11.2025









